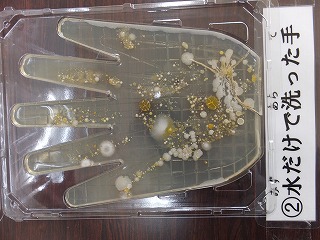
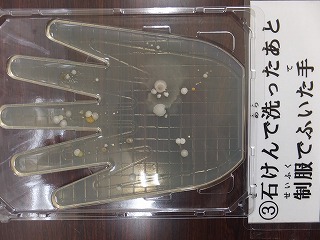
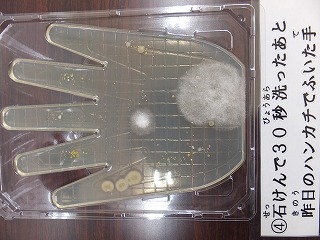

ようこそ刈安小学校ホームページへ


ようこそ刈安小学校ホームページへ

営農組合のみなさまにご協力いただいて、
全校児童で稲刈り体験をしました。
さあ、どれから刈ろうかな?
1年生は初めての体験です。とても親切にご指導いただきました。
3年生はさすがに手際もよく、大活躍でした。
「稲刈りも、もう6年目なので・・」と頼もしく話していた6年生は
今年はバインダーに挑戦です!
なんと、抜群の安定感で操作していました。(機械が重くて難しいらしいです)
ぬかるんだ田んぼに足を取られながらも
大粒の汗をかいて、一生懸命稲を刈っていました。
ここまで育つのにたくさんの人が手をかけてくださっています。
地域のみなさま、営農組合のみなさま、ありがとうございました。














































































































































〒929-0416
石川県河北郡津幡町刈安イ1番地
TEL:(076)-288-8661
FAX:(076)-288-8662
E-mail: